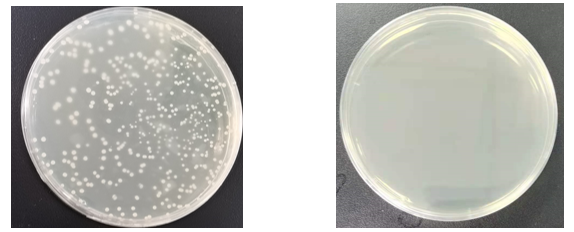

不一样的工艺,不一样的蛋白酶K
2021年7月以来,又一波新冠疫情在国内蔓延,大规模核酸检测再次开展。核酸检测标本提取效果的好坏程度,直接影响核酸检测结果的质量。特别是在这样大规模的检测过程中,如何保证标本前处理的质量成为新冠核酸筛查结果准确性的重要影响因素之一。

在核酸检测标本前处理过程中所使用到的重要核心原料——蛋白酶K是提取试剂质量保证的重要一环。
蛋白酶K是病毒采样液的重要组分,直接裂解病毒使其失活以确保检测安全,同时水解RNase/DNase以防止病毒的RNA降解。新冠提取试剂中使用的蛋白酶K,需要严格的质量控制标准,除酶活和热稳定性等理化指标外,更需要保证尽量少的杂酶污染、核酸残留以及微生物负载控制。
01
生物负载控制
生物负载是指原料或产品内部和表面带有的微生物数量。其带来的直接危害就是微生物繁殖,降解蛋白,影响产品品质和长期稳定性;同时引起严重核酸残留,污染后续检测体系。可以认为,生物负载超标的蛋白酶K将对核酸提取试剂的整体质量带来极大的影响,特别是在经过长途运输以及复杂环境下使用的产品。
生物负载可以来源于表达宿主、原材料、生产环境、工艺过程、成品储藏等整个生产环节,要控制生物负载就需要从环境控制、来料检测、工艺过程去除等方面建立全面的工艺控制流程。
瀚海通过“五道关口”控制生物负载指标,确保终产品中生物负载归零。

图2:全面工艺流程控制,保证生物负载在终产品中归零
在工艺流程控制过程中,环境控制主要是高级别生产车间的使用;包括一次性耗材的选择、过程质量检测方法的建立;在配方研究方面,对冻干工艺、液体酶保存液的研究都充分考虑对生物负载的影响。
通过以上一系统措施,瀚海蛋白酶K生物负载彻底清零,带来的直接效果就是无论冻干酶粉还是液体酶液的长效稳定性都十分出色。

图3:酶粉25℃孵育半年保持90%以上活性

图4:液体酶25℃孵育一年保持90%以上活性
瀚海对于生物负载的研究与高度关注,是高活性高稳定性蛋白酶K规模生产的诀窍之一,也是为核酸提取试剂应对常温存储、航空运输等苛刻要求保驾护航的信心来源。
02
Nickase-Free工艺
Nickase是什么?Nickase也就是切口酶,其活性可以在双链DNA的其中一条链上切断,但不会使互补链切断,形成一个有切口的双链DNA,如图5:

图5 Nickase切割DNA示意图
超螺旋双链质粒DNA经切口酶活性消化后形成切刻环状质粒DNA,如图6中pUC19质粒DNA经切口酶Nt.BstNBI消化后形成的切刻环状DNA电泳时因空间位阻效应跑的更慢。若此时再污染其他核酸酶如核酸外切酶ExoIII,pUC19质粒DNA将被降解破坏只剩下单链DNA,而只污染核酸外切酶ExoIII的pUC19质粒DNA保持结构完整不被降解。

图6:pUC19质粒DNA经切口酶Nt.BstNBI消化后形成的切刻环状DNA电泳时因空间位阻效应跑的更慢
虽然单链缺口不会立刻打断DNA,但是大多分子生物学反应是需要DNA解链成单链才能完成的,此时,单链缺口造成的负面影响与DNA双链断裂可以说是完全相同的。拿PCR实验为例,有单链缺口的DNA会在变性步骤彻底被打断,如图7所示,经竞品A蛋白酶K(Nickase残留超标)处理过的DNA样品,直接进行琼脂糖凝胶电泳,除了条带稍显模糊,貌似没有太大降解,但事实确实如此吗?我们对DNA进行热变性后再进行电泳,可以明显看出,DNA的共价结构已经出现了明显的破坏,孵育3h后,DNA已几乎完全降解,但是在经过瀚海蛋白酶K(Nickase-Free)消化3h后,目的DNA仍旧保持了良好的完整性。

图7. Nickase对于DNA完整性影响严重。采用Nickase超标的Proteinase K(A)与瀚海Proteinase K(HH)对DNA进行处理,94℃处理2min后迅速置于冰上进行热变性,结果显示Nickase污染的Proteinase K会使DNA片段化。
DNA单链损伤对于测序领域应用的影响已经得到了比较高的重视,很多科研人员将Nickase-free作为原料选择的重要指标。Nickase种类繁多,虽多数为序列特异,但识别序列很短,所以这就使得了Nickase既可以将DNA链水解为非常小的片段,但又不是随机切割,这严重影响了NGS文库的质量和最终reads分布的平衡性。而对于当下备受关注的纳米孔测序,由于DNA是以单链状态穿过纳米孔,单链断裂就会大大减少所获得的数据量。

很多人认为PCR反应对核酸部分降解不敏感,PCR反应可通过Overlap PCR的方式跨过受损区域。但是Overlap PCR实际上是截断DNA片段互为引物进行反应,所有被Nickase打断所暴露出的新的3'端都会作为“引物”与互补的DNA进行结合与延伸,这无形中增加了错配的可能性,降低了PCR反应的特异性,增加了假阳性的可能(图8A)。用瀚海PRK对DNA进行提取后,进行PCR反应,条带清晰,溶解曲线分析也显示出了良好的特异性。但用经过被Nickase污染的竞品蛋白酶K进行提取的DNA进行PCR,产生了大量的非特异性扩增,结果甚至比由4种Nickase混合设置的阳性对照更差,推测是由于竞品的Nickase污染种类更为复杂,产生了更为严重的非特异性扩增所致(图8B)。
而且,单链损伤虽然在PCR中有可能被Overlap PCR所修复,但是,这会使得PCR中的1-2个循环处于“修复循环”,从而使Ct值延后,如今IVD产品对于检测灵敏度的要求越来越严苛,这无疑会对低浓度样本的检出率造成不利影响。

图8. DNA单链断裂导致PCR异常。A.DNA单链损伤导致错配产生。B.用经Nickase污染的蛋白酶K提取的DNA作为模板进行PCR,会产生严重的非特异性扩增。
03
规模化制造
那么如何才能规模化制造Nickase-Free蛋白酶K呢?
首先通过定向进化技术提升其理化性质,得到高比活性、高稳定性突变体,这是先天条件。然后通过优化的发酵生产和纯化工艺,除掉宿主杂蛋白、DNase、RNase、微生物和Nickase。
表达细胞通过自身代谢会产生DNase、RNase和Nickase,而体内代谢产生的某些DNase经部分变性后也会转变成Nickase;体外的微生物污染,极少量的人汗液、唾沫以及眼泪中含有大量的DNase、RNase和Nickase,其中一些DNase经部分变性或被降解后也会转变成Nickase;而fg级的Nickase也会对qPCR模板的完整性带来毁灭性的破坏,这些种种因素都导致了Nickase去除和预防比RNase更加困难。
瀚海新酶通过全封闭的生产环境和多步骤层析工艺,以及严格的过程控制和检测,生产出的Nickase-Free的蛋白酶K,各项指标与国际主流品牌达到完全一致。
如图9显示,瀚海新酶蛋白酶K(固体)和国外主流品牌产品一样完全无Nickase污染,而其他4个蛋白酶K(固体)样品均有不同程度的Nickase污染。

图9. 瀚海新酶和国内外厂家RPK固体产品Nickase污染检测结果图
注:1/2:阴性对照;3/4:瀚海新酶;5/6:国外厂家A;7/8:国外厂家B;9/10:国内厂家A;11/12:国内厂家B;13/14:国内厂家C;15/16:国内厂家D.
如图10显示,瀚海新酶液体蛋白酶K和国外主流品牌同类产品一样完全无Nickase污染,而国内5个蛋白酶K液体酶样品,均有不同程度的Nickase污染。

图6. 瀚海新酶和国内外厂家液体PRK的Nickase污染检测结果图
注:1:阴性对照;2/3:瀚海新酶;4/5:国外厂家A;6/7:国外厂家B;8/9:国外厂家C;10/11:国内厂家A;12/13:国内厂家B;14/15:国内厂家C;16/17:国内厂家D;18/19:国内厂家E。
蛋白酶K作为核酸提取试剂的重要原材料,一直是瀚海新酶的重要发展项目。多年来,无论是在基本性能指标,还是核酸酶残留标准方面,瀚海新酶一直向行业高质量标准看齐,并不断改进生产工艺,其中全流程质量检测指标超过100项,质量控制文件超过50条。

正是瀚海新酶对于高品质的追求,才让蛋白酶K荣获了2020年“创之星”中国体外诊断年度创新优秀产品-上游原材料金奖,同时在国家科技部2020年“科技助力”重点专项中成功入选。产品品质更是在市场上得到了分子诊断龙头企业的充分认可,进入到多家核酸提取试剂盒主流生产企业供应链。

在这样一个大变革时代,瀚海新酶坚持“追求卓越”的价值观,不断加大研发投入,不断推出新的产品线,且一如既往保持高品质路线。在通往“世界一流核心酶原料产品与服务供应商”的道路上,瀚海的追求永志不懈!
咨询
- 1159
- 点赞
- 复制链接
- 举报
